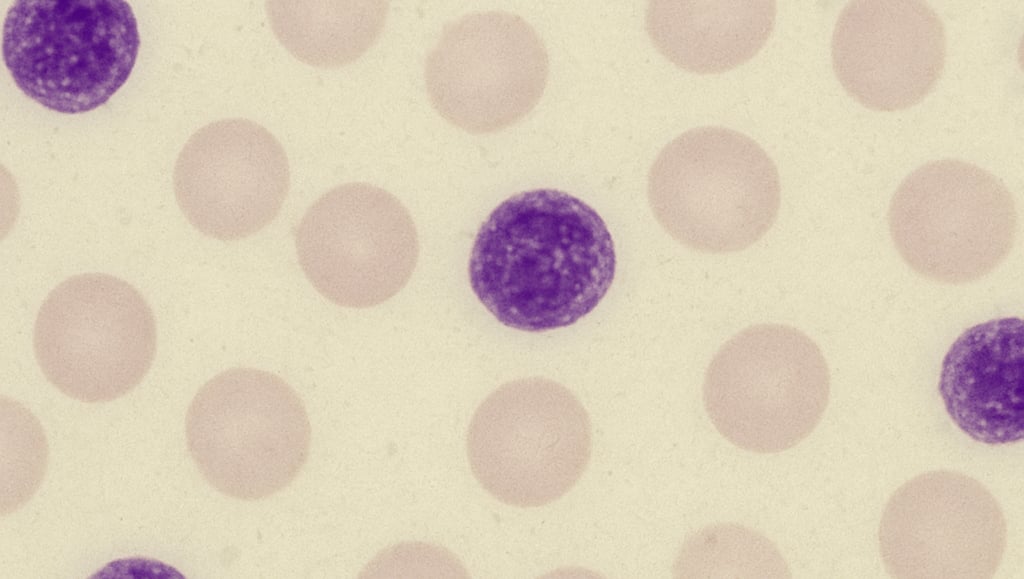
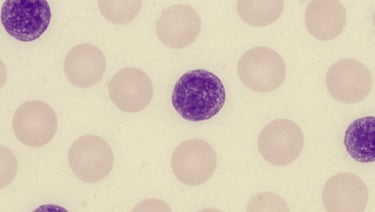

Dengue e Plaquetas Baixas: Por Que a Contagem Demora a se Recuperar?
Entenda como a dengue afeta a produção de plaquetas, por que a recuperação pode demorar e quais cuidados ajudam a evitar complicações graves
04/05/2025
3 min ler

A dengue é uma das infecções virais mais prevalentes no Brasil e, além da febre alta e dores no corpo, uma das consequências mais temidas é a queda acentuada das plaquetas no sangue. Mas mesmo após a melhora dos sintomas, muitos pacientes se perguntam: por que as plaquetas demoram tanto a subir novamente?
Neste artigo, entenda como a dengue afeta o sistema hematológico, o papel das plaquetas na defesa do corpo e os motivos para a recuperação lenta — além de saber o que realmente funciona na fase de recuperação.
O que são plaquetas e por que elas caem na dengue?
As plaquetas, ou trombócitos, são células sanguíneas responsáveis pela coagulação do sangue. Elas agem como “soldados de emergência”, ajudando a conter sangramentos ao formar tampões em vasos danificados.
Na dengue, o vírus ataca diretamente a medula óssea, que é a fábrica natural de células do sangue. Isso reduz temporariamente a produção de plaquetas. Além disso:
Há destruição periférica de plaquetas pelo sistema imune;
Aumenta a permeabilidade vascular, levando à diluição sanguínea;
Algumas plaquetas são retidas ou sequestradas no baço.
Tudo isso resulta em plaquetopenia, que pode ser leve, moderada ou grave — especialmente nos casos de dengue hemorrágica.
Quando as plaquetas começam a cair?
Geralmente, a contagem de plaquetas começa a cair por volta do 3º ao 5º dia após o início da febre. O ponto mais crítico costuma ocorrer entre o 5º e o 7º dia, período em que há maior risco de complicações hemorrágicas.
Atenção especial deve ser dada quando as plaquetas caem abaixo de 100.000/mm³, e risco aumentado de sangramento em casos abaixo de 50.000/mm³.
Por que a contagem de plaquetas demora para se recuperar?
Mesmo após o desaparecimento dos sintomas (febre, dor, prostração), o organismo ainda está:
Combatendo o vírus residual no sangue;
Tentando reorganizar a produção normal da medula óssea;
Corrigindo danos vasculares e inflamatórios;
Em estado de convalescença, exigindo repouso e hidratação.
Por isso, em muitos casos, a recuperação da contagem de plaquetas só acontece gradualmente, ao longo de 7 a 14 dias após o início da infecção.
O que realmente ajuda na recuperação das plaquetas?
Embora sucos e chás naturais (como folha de mamão, suco de goiaba e beterraba) sejam populares, não há evidência científica robusta de que eles acelerem a recuperação.
As recomendações médicas mais eficazes incluem:
Hidratação intensiva com água e sais minerais;
Repouso absoluto, especialmente durante o período crítico;
Monitoramento médico diário com hemograma;
Alimentação rica em proteínas, ferro e vitaminas do complexo B;
Uso de medicamentos apenas com orientação (evitar AAS e anti-inflamatórios).
A transfusão de plaquetas é indicada apenas em casos graves, quando há risco de sangramento ativo e plaquetas <10.000/mm³.
Quando se preocupar e procurar ajuda?
Procure atendimento médico imediato se houver:
Sangramento nasal ou gengival;
Manchas vermelhas na pele (petéquias);
Vômitos com sangue ou fezes escuras;
Dor abdominal intensa ou tontura;
Queda progressiva das plaquetas mesmo após o 7º dia.
Em Síntese
A recuperação das plaquetas após a dengue é um processo natural e pode ser mais lento do que os sintomas aparentes indicam.
Respeitar o tempo do corpo e seguir as orientações médicas é essencial para evitar complicações e garantir uma recuperação completa.
📘Descubra o Poder do NS1 na Detecção Precoce da Dengue!
Aprenda como o antígeno NS1 pode salvar vidas com diagnósticos mais rápidos e eficazes.
📘 Adquira agora o e-book "NS1: O Antígeno da Dengue" e aprofunde seu conhecimento com linguagem clara, prática e embasada.

